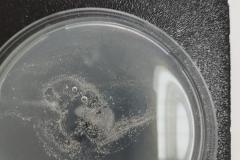
1739690106002
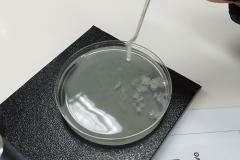
1739690105996
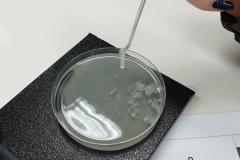
1739690105990
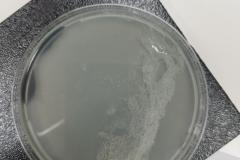
1739690106009

Εργαστήριο Βιολογίας: Νουκλεϊκά Οξέα και Μικροοργανισμοί

Στο εργαστήριο του σχολείου μας, υλοποιήσαμε εργαστηριακές ασκήσεις στο μάθημα της Βιολογίας, Γ Λυκείου.
Απομονώσαμε νουκλεϊκά οξέα από ώριμη μπανάνα και φτιάξουμε θρεπτικό υλικό για καλλιέργειες μικροοργανισμών.
Ήταν μία αρκετά εποικοδομητική και αλληλοεπιδραστική εργαστηριακή άσκηση.
Δείτε φωτογραφίες από την δημιουργικότητα της ομάδας.